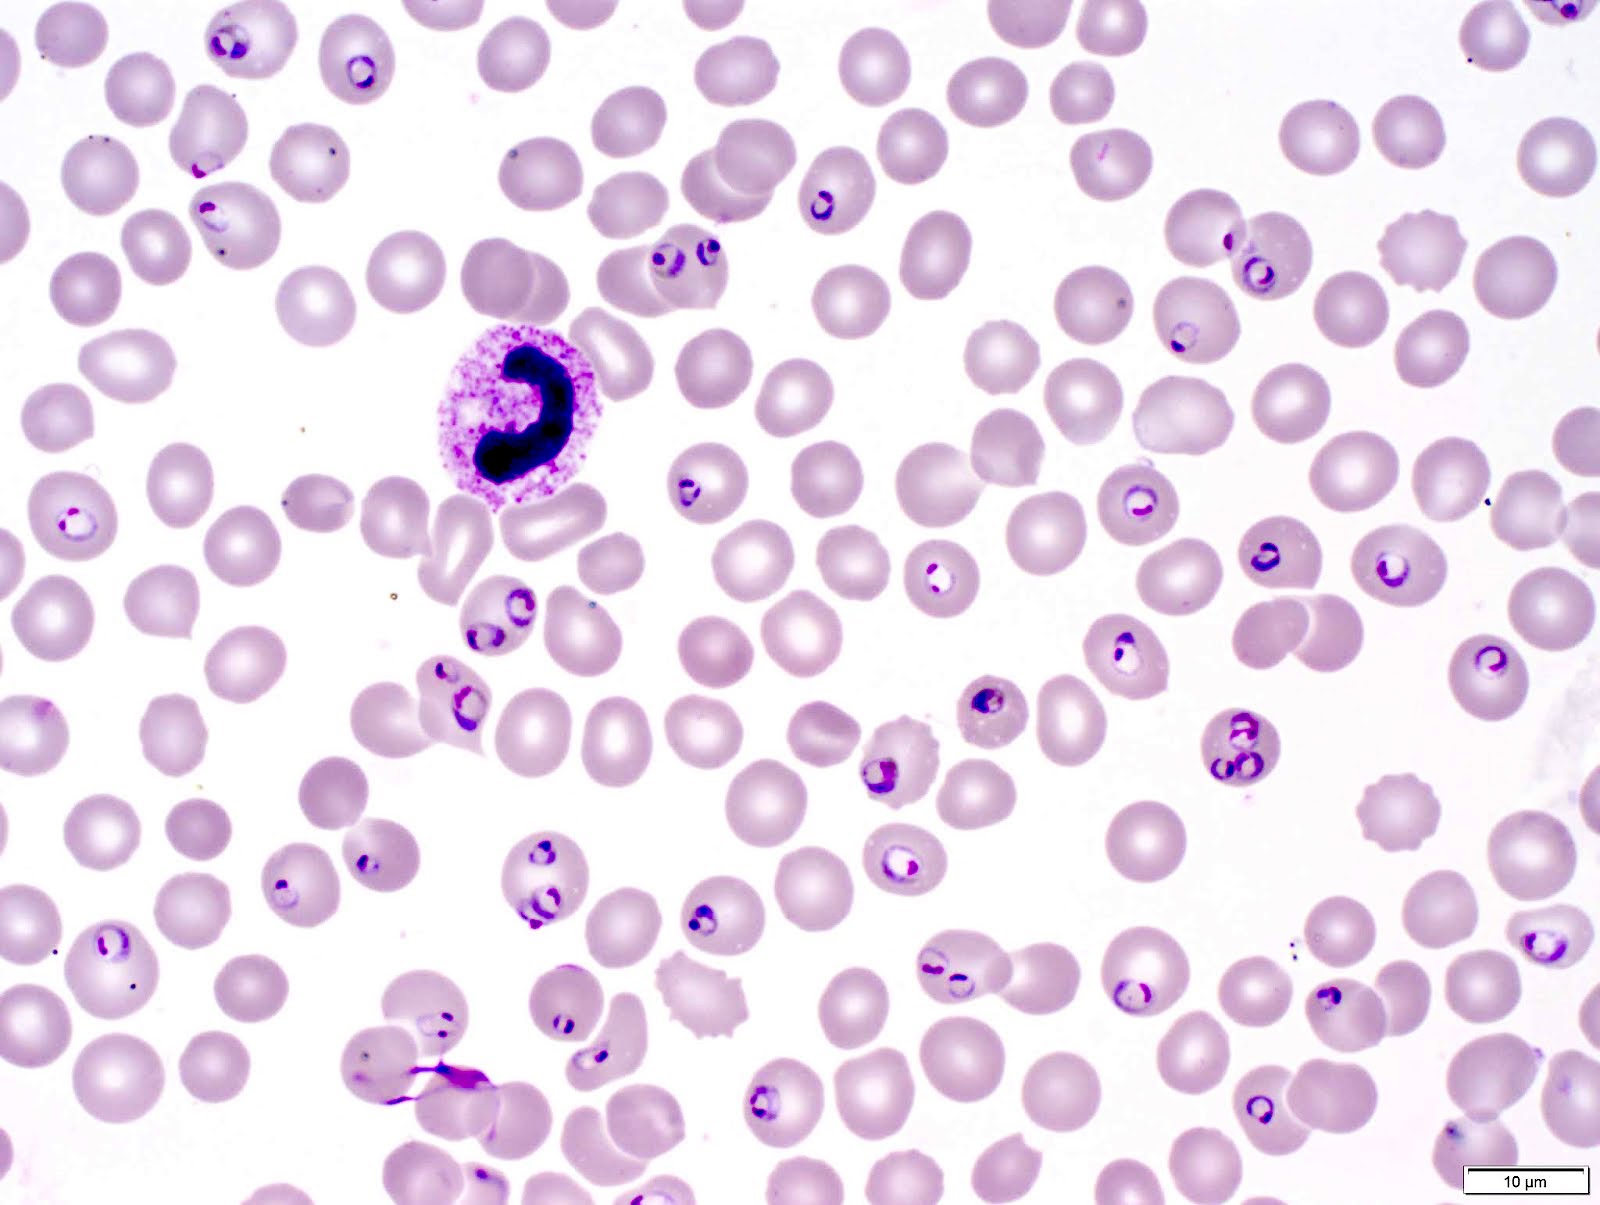

Medical Mystery of the Week
You have recieved your COVID19 immunizations but still participate in Telemedicine.
A friend of yours is a missionary in rural Chile, South America. He sends you photographs
(see below) of a critically ill 35-year-old woman, her temperature recordings, and
her urine sample.
What is your diagnosis, what test(s) would you order to confirm your suspicions,
and what treatment, if any, do you recommend? What is the significance of her posturing?
What might a fundiscopic examination reveal?
DIAGNOSIS: Cerebral malaria due to infection with Plasmodium falciparum. The patient demonstrates decerebrate posturing (Panel A below), a quotidian fever
(Panel B below), and excretes a dark muddy urine filled with urobilinogen and hemoglobin
(Blackwater fever, Panel C below) - all characteristic of a severe P. falciparum infection.
The diagnosis of malaria is confirmed by microscopic examination of the peripheral
blood (Panel D below), rapid diagnostic tests (RDTs), and/or real-time polymerase
chain reaction (PCR) assays.
P. falciparum is entrenched in poor areas of the world with climates suitable for transmission by
the aedes mosquito (see Panel E below). This organism is estimated to cause over 220
million new cases and over 400,000 deaths annually, with the highest mortality occurring
in children under the age of 10.
P. falciparum may be resistant to most antimicrobials, including artesunate. Fortunately, there
is now evidence that a newly studied vaccine may reduce the mortality of malaria in
children.

Panel A: The patient demostrates decerebrate rigidity (involuntary extensor positioning
of the arms and legs and flexion of the hands and feet) due to damage caused by P. falciparum. Decerebrate positioning is a tonic, static reflex that is maintained by the reticular
formation and vestibulospinal system. The lesions are usually in the ascending and
descending white matter tracts of the midbrain between the red nucleus and lower vestibular
nuclei.
A hallmark of cerebral malaria is the sequestration of mature parasitized red
blood cells in the cerebral microvasculature; sequestration may also be seen in the
retinal arteries. Cerebral malaria is characterized by Impaired consciousness, seizures,
brain swelling, and a fatality rate up to 20% even when appropriate clinical management
is provided.

Panel B. The patient has a quotidian fever (daily spikes in temperature) characteristic of P. falciparum. Tertiary fevers (temperature spikes every 3 days) are characteristic of P. vivax, and quartinary fevers (temperature spikes every 4 days) are characteristic of P. malariae.

Panel C. The patient has "Blackwater fever" (massive intravascular hemolysis) caused by P. falciparum. The urine contains high levels of hemoglobin and urobilinogen due to the infection-related hemolysis.
Panel D. Wright-Giemsa stain of the peripheral blood of a patient with P. falciparum malaria. A single eosinophil is present in this blood sample. Patients with sickle cell anemia (not shown) are protected against severe infection with P. falciparum.

Panel E. World wide distribution of clinically evident malaria. Although malaria
is rare in Chile, the presented case had spent time in rural Peru, a region endemic
to Falciparum malaria.
Stout Drive Road Closure